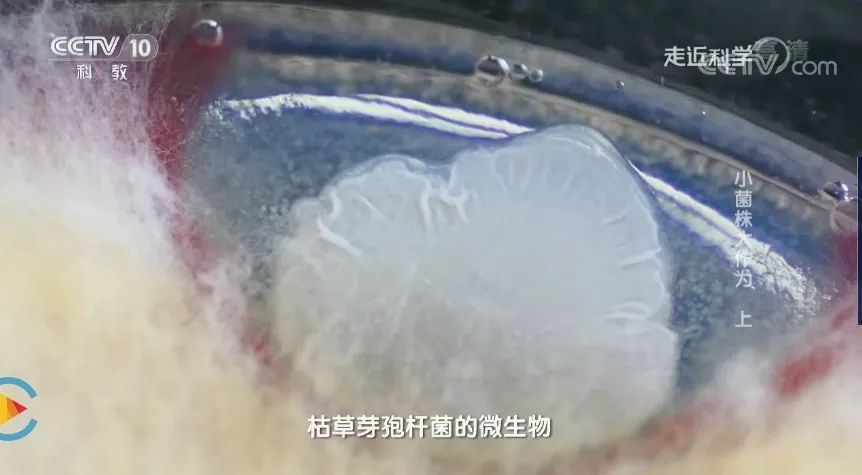

我国是世界上最大的抗生素生产和使用国,同时也是细菌耐药性的重灾区。抗生素滥用问题在医疗特别是畜牧业领域尤其严重。畜牧业养殖户普遍将饲用抗生素添加到饲料中,当做保健品给动物防病,促进动物生长。而这会导致“超级细菌”的出现,污染环境,损害人们身体健康。无抗饲养是畜牧业健康发展的目标,如何减少畜牧业抗生素的使用已是全世界共同关注的话题。
枯草芽孢杆菌广泛存在自然界中,对人畜无毒无害,不污染环境,是一类公认的益生菌,具有提高动物免疫力等多种功能。因此,在国家大力提倡无抗养殖的大环境下,枯草芽孢杆菌成为替代饲用抗生素的一种。然而,市场上已有的枯草芽孢杆菌在促进动物生长方面的效果不够显著,价格却高于抗生素,这也成为了取替饲用抗生素的瓶颈。中国科学院遗传与发育生物学研究所胡赞民研究团队通过大量筛选获得了一株优良的枯草芽孢杆菌菌株HF1。该菌株在调整动物肠道菌群、提高动物免疫力、促进动物健康生长等方面效果显著。
为了更好地让百姓了解枯草芽孢杆菌的益生作用,中央电视台十套科教频道《走近科学》栏目以胡赞民研究组的益生菌菌株HF1为主题,拍摄了科教专题片《小菌株大作为》。该专题片介绍了益生菌的分离、实验室活性测定、工业化制备及应用,于2018年3月19日至20日在中央电视台十套科教频道分上、下两集播出。
【走进科学】小菌株大作为(上)
图文解读

中科院遗传发育所发现一种替换养殖业中抗生素使用的益生菌——枯草芽胞杆菌
枯草芽胞杆菌广泛存在于大自然中,土壤中便可以获取这种菌株

芽胞杆菌进行热处理,可减少其它菌种,芽胞杆菌可形成芽胞,降低其它细菌种类,富含芽胞

中国年抗生素使用量16.2万吨,世界的一半;其中一半用于牲畜。

中国抗生素使用率70%,是欧美国家2倍。但实际需要使用者不到为20%。

养殖的饲料中会添加抗生素,一些肉蛋抗生素超标,会导致人被动使用抗生素

长期使用导致大量耐药菌产生,在人类感染下,可能会无药可救。
为什么养殖要使用抗生素呢?

使用抗生素,不仅可以减少动物细菌感染,而且可以促进生长。
禁用抗生素添加,什么可以作为替代品呢?


微生态替代抗生素的方法是近几年兴起,主要使用枯草芽胞杆菌,调节鸡肠道。会杀灭体内的有害菌,
微生态就是促进微生物生长的物质,活的微生物制剂,来调节肠道菌肠,从而使畜禽的免疫力得到提升,增强防病抗病的能力。
现给大家提几个问题:
这种菌是如何在自然界中筛选出来的呢?
添加杆草芽胞杆菌对动物有什么影响呢?
想知道答案,请观看《小菌株大作为(下)》吧!!!
猜你喜欢
10000+:菌群分析 宝宝与猫狗 梅毒狂想曲 提DNA发Nature Cell专刊 肠道指挥大脑
文献阅读 热心肠 SemanticScholar Geenmedical
16S功能预测 PICRUSt FAPROTAX Bugbase Tax4Fun
生物科普: 肠道细菌 人体上的生命 生命大跃进 细胞暗战 人体奥秘
写在后面
为鼓励读者交流、快速解决科研困难,我们建立了“宏基因组”专业讨论群,目前己有国内外5000+ 一线科研人员加入。参与讨论,获得专业解答,欢迎分享此文至朋友圈,并扫码加主编好友带你入群,务必备注“姓名-单位-研究方向-职称/年级”。技术问题寻求帮助,首先阅读《如何优雅的提问》学习解决问题思路,仍末解决群内讨论,问题不私聊,帮助同行。

学习16S扩增子、宏基因组科研思路和分析实战,关注“宏基因组”
 点击阅读原文,跳转最新文章目录阅读
点击阅读原文,跳转最新文章目录阅读























 1068
1068

 被折叠的 条评论
为什么被折叠?
被折叠的 条评论
为什么被折叠?








